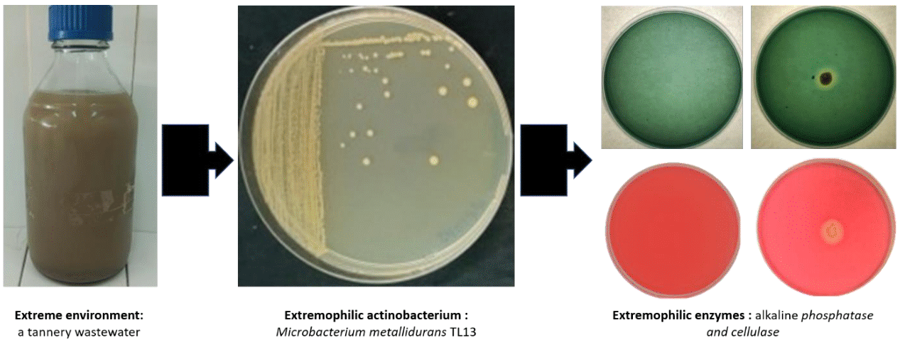

MOJ
eISSN: 2576-4519


Review Article Volume 8 Issue 1
1LBVBGR-LR11ES31, Higher Institute of Biotechnology of Sidi Thabet (ISBST), University of Manouba, Tunisia
2LAPVA-LR16ES20, National Engineering School of Sfax (ENIS), University of Sfax, Tunisia
3Common Services Unit “Bioreactor Coupled with an Ultrafilter”, ENIS, University of Sfax, Tunisia
Correspondence: Mohamed Neifar, Laboratory of Plant Improvement and Agro-Resources Valorization (LAPVA-LR16ES20), National Engineering School of Sfax, University of Sfax, Road of Soukra km 4, Sfax, 3038 Tunisia, Tel 21628762783
Received: August 19, 2024 | Published: September 6, 2024
Citation: Gorrab A, Ouertani R, Souii A, et al. A Comprehensive review on the properties and applications of extremozymes from extremophilic actinobacteria. MOJ App Bio Biomech. 2024;8(1):76-85. DOI: 10.15406/mojabb.2024.08.00213
Actinobacteria are ubiquitous microorganisms found in soil, plants tissues and aquatic environments. They have an exceptional potential for producing secondary metabolites of pharmaceutical interest. In addition, they are good producers of enzymes effective in breaking down various organic substances. In recent years, the number of studies on enzymes produced by extremophilic actinobacteria has increased considerably thanks to their unusual mechanisms of action, their stability and resistance to denaturation as well as structural novelties allowing them to be promising and efficient for wide applications in many products and processes particularly in detergent, food and beverage, animal feed, leather, textile, pulp and paper, biofuel, cosmetic and pharmaceutical industries. This review summarizes the latest experimental data on extremozymes, produced by extremophilic actinobacteria. It focuses on the description of the producing actinobacteria, their biochemical and physicochemical properties and their potential industrial applications for the development of a bioeconomy, with particular emphasis on thermophilic, psychrophilic, acidophilic, alkaliphilic and halophilic hydrolases such as amylases, cellulases, xylanases, pectinases, chitinases, proteases, lipases and phospholipases.
Keywords: extremophilic actinobacteria, green biocatalysts, biobased economy, extremozymes, biochemical properties, industrial applications
The global industrial enzymes market is estimated to be worth US$5.6 billion in 2019, and this figure is expected to enhance at an average annual growth rate of approximately 6.4% from 2020 to 2027.1 Enzymes are used as active ingredients, additives or manufacturing aids in many industrial sectors. Enzyme based technologies have been developed to meet the global needs of the detergent, leather, textile, energy, food and feed markets. One of the recent green and sustainable approaches to achieve catalysis in harsh industrial conditions is to use microbial extremozymes.2–4 Indeed, extremophile microorganisms (thermophiles, psychrophiles, acidophiles, alkaliphiles, halophiles, barophiles, metallophiles, xerophiles, radiophiles, metallophiles, etc.) have abilities to colonize the most hostile environments such as volcanic zones, hydrothermal sources, hypersaline and alkaline lakes, desert sediments, cold oceans, and industrial effluents. They develop several strategies to overcome several biotic stresses caused by diverse pathogens.3 They are also able to survive unusual conditions of temperatures, salinity, pressure, heavy metals, radiation, acidic or basic pH, drought, cold or a combination of different abiotic stresses (polyextremophiles).5–7
Actinobacteria play a vital role in many biological processes including biogeochemical cycles, bioweathering, bioremediation and plant growth promotion.8–10 They are widely recognized for their metabolic versatility and resistance to hazardous environmental conditions. Actinobacteria produce a broad spectrum of bioactive metabolites with high commercial value, e.g. pharmaceuticals, nutraceuticals, antitumor agents and plant growth regulators, making them a prime target for the discovery of novel bioactive compounds.11–13 They are also a great source of several industrial enzymes, such as proteases, lipases, cellulases, amylases, pectinases, chitinases, among others.14–19 In recent years, with continued advances in sequencing technology and bioinformatics tools, numerous studies have focused on exploring actinobacteria that thrive in extreme conditions to unearth the specific characteristics of theirs extremozymes.3 Their unique structural features and adaptations allow them to resist against denaturation at extremely conditions/environments, and efficiently catalyze reactions in organic solvents and unconventional media.20–26 This review summarizes, based on representative examples, the main extremozymes produced by extremophilic actinobacteria, focusing on their bio-physico-chemical properties and their industrial uses.
Biological and chemical diversity of actinobacteria
Actinobacteria represent one of the oldest phyla in the Bacteria domain.13 They have quite variable morphologies ranging from cocci to branched filaments. Members of this phylum are characterized by their high GC content ranging from 42% (Gardnerella vaginalis) to 74.4% (Kineococcus radiotolerans).27,28 The Actinobacteria phylum currently includes six classes, namely Actinobacteria, Acidimicrobiia, Coriobacteriia, Nitriliruptorales, Rubrobacteria and Thermoleophilia29 (Figure 1). The sixteen orders of the class Actinobacteria are: Actinomycetales, Bifidobacteriales, Catenulisporales, Corynebacteriales, Cryptosporangiales, Frankiales, Glycomycetales, Jiangellales, Kineosporiales, Micrococcales, Micromonosporales, Propionibacteriales, Pseudonocardiales, Sporichthyales, Streptomycetales and Streptosporangiales.27 The phylogeny of Actinobacteria remains controversial due, among other things, to the choice of datasets and phylogenetic methods.30–34 For example, according to the study by Sen et al,30 the order Micrococcales is subdivided into Micrococcales (Kocuria, Rothia, Micrococcus, Arthrobacter, Tropheryma, Microbacterium, Leifsonia and Clavibacter), Cellulomonales (Beutenbergia, Cellulomonas, Xylanimonas, Jonesia and Sanguibacter) and Brachybacteriales (Brachybacterium). Based on cell wall morphology and chemotype, species of the genus Streptomyces of the family Streptomycetaceae are considered to be the most studied actinobacteria due to their interesting roles in ecology, industry and biotechnology.13

Figure 1 Proposed taxonomy for Actinobacteria in the forthcoming Bergey’s Manual of Systematic Bacteriology.29
Biotechnologically and industrially, actinobacteria are considered valuable bacteria since they are exploited for the production of biomolecules of interest (Figure 2). More than 10,000 bioactive molecules have been produced by actinobacteria, representing approximately 45% of all bioactive microbial metabolites discovered to date. They produce clinically useful antibiotics as well as other pharmaceutical products including anticancer agents, immunostimulants, immunosuppressants, antioxidants and antiparasitics.11–13,35–38
Actinobacteria are increasingly known for their capacity to produce many industrially important enzymes, such as ligninases, glycosyl hydrolases (cellulases, xylanase, amylases, etc.), proteases and lipases/esterases. These enzymes are used in the bioconversion of numerous agricultural and agro-industrial substrates and wastes into high added value bioproducts.14–19,39–44
Strategies for discovering extremozymes producing extremophilic actinobacteria
Extremophilic microorganisms have the ability to live in various terrestrial and aquatic ecological niches under extreme conditions by adapting to ranges of temperature (55°C to 121°C and -2°C to 20°C) , alkalinity or acidity (pH > 8, pH < 4), salinity (NaCl or KCl 2-5 M), pressure (>500 atmospheres), radiation (UV resistance > 600 J/m) , heavy metals (arsenic, cadmium, copper, chromium, iron, nickel, lead, zinc and mercury), etc.3 These extremophiles are classified into thermophiles, psychrophiles, alkalophiles, acidophiles, halophiles, piezophiles, metalophiles, etc. depending on the extreme biota in which they grow and the abiotic environmental stressors they can resist and tolerate. The most representative actinobacterial genera for each extremophilic group were listed in figure 3. Extremophilic actinobacteria have developed several strategies of adaptation to extreme conditions such as antibiosis, variation of metabolic modes (autotrophy, heterotrophy and saprobes) and the secretion of extremozymes stable at harsh conditions such as high temperature, alkalinity and salinity. Some actinobacteria are adapted to survive more than one type of extreme environment and are therefore called polyextremophiles.5–7
The classic approach to discover new extremozymes consists to cultivate microorganisms followed by a screening of the desired enzymes.27,45–47 Although many extremozymes with improved properties for industrial applications have been isolated from extremophiles using the classical culturable approach, approximately 99.9% of extremophilic actinobacteria (as for other microorganisms) cannot be grown using traditional laboratory techniques. Fortunately, metagenomic approaches have recently been developed to discover new extremozymes-encoding genes directly from uncultured microorganisms.3 Putative enzymes are identified on the basis of their conserved sequences or on the basis of their function and specific enzymatic activity. The latter is now the most frequently used technique to screen new extremozymes originating from extremophilic Actinobacteria. Furthermore, due to rapid advances in microbial genome sequencing technologies, increasing progress has been made in studying the diversity and biotechnological potential of actinobacteria. Indeed, the genomes of numerous terrestrial and marine extremophilic actinobacteria have been recently annotated, analyzed and evaluated, which provides valuable information related to these microbial extremophiles and their catalytic potential. Genomic annotation makes it possible to properly understand the mechanisms of adaptation of these extremophiles to extreme conditions and to identify the structural and catalytic specificities of their extremozymes. As an illustrated example, Figure 4 and 5 showed the genomic traits of the polyextremophilic actinobacterium Microbacterium metallidurans TL13 and the 3D structure of its thermostable heavy-metal reductases.48
Figure 4 Microbacterium metallidurans TL13: an extremozyme-producing actinobacterium isolated from a tannery wastewater.

Figure 5 (a) RAST annotation summary of the genome of halo-thermo-alkali-tolerant, metallophilic plant growth promoting actinobacterium Microbacterium metallidurans TL13 (Taxonomy ID: 69370; genome size: 3,587,460 and GC Content: 70.7). The RAST annotation tool assigns names and functions to protein-coding genes via their subsystem technology. The green color represents features that are found in RAST subsystem. The blue color represents features not assigned to a subsystem. The draft genome sequence suggests potent metabolites candidates that are essential for survival under multiple environmental extreme conditions, such as high salinity, alkalinity and the presence of critical heavy metal concentrations.
(b) Swiss model 3D-structures of selected thermostable arsenate reductase (MM: 14.30 KDa; pI: 4.64; AI: 90.90), chromate reductase (MM: 20.20 KDa; pI: 4.69; AI: 92.00) and mercuric reductase (MM: 49.18 KDa; pI: 5.48; AI: 94.35) of the metallophilic strain TL13. The corresponding in silico properties were determined by Expasy-Prot Param tool (http://web.expasy.org/protparam/). All proteins showed aliphatic index (AI) values of more than 90 indicated that they are highly thermo-stable.
Adaptation mechanisms and properties of actinobacterial extremozymes
The majority of enzymes currently on the market come from mesophilic micro-organisms, often inhibited by the extreme conditions of many industrial processes. Although these enzymes appear to perform well in certain industrial applications, the enzyme market remains insufficient to meet industrial demands, largely due to their poor stability under industrial conditions.49 Industrial processes often require biocatalysts capable of withstanding a wide range of harsh conditions, including temperature, pH and salinity, while exhibiting high biocatalysis/bioconversion rate and reproducibility. Consequently, the enhanced stability and activity of extremozymes make them promising alternatives to ordinary processes conferring considerable economic potential in various industries. It's worth mentioning that microbial extremozymes use a variety of mechanisms to tolerate conditions. (Figure 6)

Figure 6 Protein adaptations and unique structural features of some extremozymes.49–62
Thermophilic enzymes are characterized by maximum activity at temperatures between 50 and 125°C.50 Disulfide bonds play a major role in thermal stability, due in part to the presence of disulfide ponds that reduce the entropy of the unfolded protein form;51–53 Other factors involved in maintaining the conformation of thermophilic extremozymes include the presence of loops and short helices, a good surface charge with internal hydrophobic amino acids.50,54 The three-dimensional structures of thermophilic enzymes are generally similar to those of their mesophilic counterparts, with some differences such as a greater presence of charged residues on their surface. Among the different types of extremozymes, thermophiles are the most studied scientifically and the ones that have attracted the most attention from manufacturers in view of their benefits for industrial processes. High temperatures increase the solubility of polymeric substrates, reduce the risk of contamination, promote faster reactions and improve solvent miscibility. Psychrophilic enzymes are active and stable at low temperatures between -20 and 10°C.55 They preserve their enzymatic activities at low temperatures unlike mesophiles thanks to a low arginine/lysine ratio, little proline and plenty of glycine in the structure, increased surface hydrophobicity, few secondary structures, weaker interactions of hydrogen bonds, disulfide bridges and electrostatic interactions and.56,57 Psychrophilic enzymes improve the cost-effectiveness and efficiency of low-temperature industrial processes and reduce environmental impact.
Alkaliphilic enzymes have maximum activity and stability at pH values above 9. They have more alkaline isoelectric points than their neutrophilic counterparts, due to the abundance of basic amino acids such as arginine and histidine, and a reduction in acidic amino acids such as glutamate.49 Arginine residues form ionic bonds with aspartate residues, enhancing enzyme stability under alkaline conditions.58 Acidophilic enzymes have maximum activity and stability at pH values below 3. They have acidic isoelectric points due to the abundance of acidic amino acids (aspartate, glutamate).59 At very low pH, most surface amino acids are protonated, leading to a reduction in negative charges and protein stabilization.
Halophilic enzymes are characterized by maximum activity and stability at high NaCl concentrations exceeding 1.5 M. Halophilic enzymes generally have an acidic isoelectric point with an abundance of acidic amino acids (aspartic and glutamic acids) on the surface of the enzyme.60 These amino acids have high water retention allowing the protein to remain soluble in conditions of dehydration caused by high salinity. Halophilic enzymes also tolerate organic solvents since this lower water activity in the same way as high salinity. Another adaptive mechanism is their weak hydrophobic interactions which result in good protein flexibility at high NaCl concentrations.61 Structural analyzes revealed major differences between nonhalophilic and halophilic enzymes. The former contains higher percentages of protein surface serine and threonine and low hydrophobicity amino acids, aspartic and glutamic acids and lower percentages of basic amino acids such as lysine than enzymes non-halophilic. This favors the creation of a greater number of salt bridges and electrostatic interactions. In addition, negative surface charges are involved in protein solvation and prevention of protein denaturation and aggregation.49
Polyextremophilic Enzymes are currently attractive for biotechnology because they resist to multiple harsh conditions, such as: pH, temperature and salinity.49 The search for new unique polyextremophilic enzymes is a valuable activity for which extremophilic actinobacteria producers have been neglected. The structurally favored resistance of polyextremophilic enzymes is still poorly understood.62
Industrially important hydrolytic actinobacterial extremozymes: Streptomyces species as model producers
A huge number of actinobacterial enzymes are being produced commercially and used in various industries (Figure 7).63–68 Some important extremophilic glycosyl hydrolases, lipase/esterases and proteases produced by actinobacteria particularly Streptomyces species are briefly described below (Table 1).
| Extremozymes | Producing strain | Enzymesproperties | Potentialapplications | References |
| Extremophilic amylases | S. fragilis DA7-7 | Thermo-halo-alkali-stable,retained activity in presence of detergents | Use in brewery, bakery, detergent, saccharification and starch liquefaction | 69 |
| Streptomyces sp. TDI-10, Streptomyces sp. TDI-12Streptomyces sp. TDI-13 | Thermostable | Antifungal andbioleaching | 70 | |
| Streptomyces sp. No. 4 | Thermo-alkali-stable | Hdrolyze of blue starch and production of glucose and maltose | 71 | |
| Streptomyces strain A3 | Thermo-halo-alkali-stable,retained activity in presence of oxidents and detergents | Detergents, food and pharmaceutical industries | 72 | |
| Extremophilic cellulases | S. drozdowiczii M7a | Thermostable, retained activity in the presence of detergents | Detergent and textile industries | 73 |
| Streptomyces DSK59 | Acido-thermostable | Hydrolyse of pretreated sorghum stover and liberation of reducing sugars | 74 | |
| Streptomyces sp. strain SirexAA-E (SACTE) | Thermostable | Deconstruction of lignocellulosic plant biomass into small polysaccharides and free sugars | 75,76 | |
| Extremophilic hemicellulases (xylanases and mannanases) | S. griseorubens LH-3 | Thermostable | Biobleaching of eucalyptus kraft pulpProduction of short-chain xylooligosaccharids | 77 |
| S. ipomoea CECT 3341 | Thermo-alkalistable | Biobleaching of pine kraft pulps | 78 | |
| Streptomyces galbus NR | Thermoalkalistable | Liberation of reducing sugars and improvement of pulp bleachability | 79 | |
| S. olivaceus (MSU3) | Thermo-halo-alkalistable | Convertion of the pretreated agro-wastes into bioethanol | 80 | |
| Streptomyces sp. CS628 | Alkali-thermostable | Biobleaching of kraft pulp and xylooligosaccharides production | 81 | |
| S. chartreusis L1105 | Alkali-thermostable | xylooligosaccharide production | 82 | |
| Extremophilic pectinases | S. hydrogenans YAM1 | Thermostable | Production of active compound from fruit wastes and removal of fibrous pollutants from different environments | 84 |
| Streptomyces sp. S27 | Alkalistable | Use in alkaline industries such as textile | 85 | |
| S. lydicus | Thermostable and active at neutral pH | Banana fiber processing | 86 | |
| S. halstedii ATCC 10897 | Thermostable | Juice clarification | 87 | |
| Extremophilic chitinases | S. chilikensis RC1830 | Thermostable | Production of chito-oligo-saccharides | 88 |
| St. venezuelae P10 | Thermal stability,pH tolerant, and antifungal properties | Potential use as biocontrol agents | 89 | |
| Streptomyces mutabilis | Thermostable | Synthesis of N-acetylD-glucosamine, in production of single cell protein (SCP) and for bioconversion of chitinwastes | 90 | |
| S. violascens NRRL B2700 | Thermostable | Applications in industrial, medical and commercial fields | 91 | |
| S. violaceusniger | Thermostable | Antagonistic effect of this bacterium against wood rotting fungi | 92 | |
| Extremophilic proteases | S. fungicidicus MML1614 | Alkali-thermostable | Leather, pharmaceutical detergents, food and brewing | 93 |
| S. koyangensis TN650 | Alkaline, detergent-stable, solvent-tolerant | Application in detergent formulations and non-aqueous peptide biocatalysis | 94 | |
| Streptomyces sp. MAB18 | Alkali-thermostable, antioxydant properties | Use as supplementary protein and antioxidant in the animal feed formulations | 95 | |
| Streptomyces sp. AB1 | Alkali-thermostable, stability in organic solvents | Applications in detergent formulations, dehairing during leather processing, and non-aqueous peptide biocatalysis | 96 | |
| Streptomyces sp. | Alkali-thermostable | Useful for biotechnological process involving keratin hydrolysis or in the leather industry | 97 | |
| S. gulbargensis | Alkali-thermostable | Valorization of keratin-containing wastes or in the leather industry | 98 | |
| Streptomyces sp. DP2. | Alkali-thermostable | Production of protein hydrolysates, for the film industry, and in waste processing | 101 | |
| Lipases/esterases | Streptomyces sp. OC119-7 | Organic solvent-tolerant | Biodiesel production | 102 |
| Streptomyces sp. CS273 | Alkaline, organic solvent-tolerant | Transesterification of waste cooking oil | 103 | |
| S. violascens OC125-8 | Alkali-thermostable | Oily wastewater treatment | 104 | |
| S. pratensis MV1 | Organic solvent-tolerant | Enzymatic improvement of n6/n3 ratio in polyunsaturated fatty acids from fenugreek seed oil | 105 | |
| Streptomyces sp. W007 | Thermostable, organic solvent tolerant | Potential applications in industries for oil modificationand production of partial glyceride | 106 | |
| S. thermocarboxydus ME168 | Thermostable | Sugar ester synthesis | 107 | |
| S. lividans TK64 | Alkali-thermostable | Synthesis of polyesters, optical prodrugs, and food additives | 110 | |
| S. coelicolor A3(2) | Cold-active, alcohol and organic solvent tolerant | Organic synthesis of short-chain esters such as flavors | 112 | |
| Extremophilic phospholipases | S. cinnamoneum SK43.003 | Acido-thermostable | Convertion of phosphatidylcholine to phosphatidylserine | 114 |
| S. olivochromogenes CS528 | Alkali-thermostable | Lipid industry | 115 | |
| S. violaceoruber AS‐10 | Thermostable | Food manufacturing processes, i.e. egg processing, baking processes, degumming of fats and oils and milk processing for cheese production | 116 |
Table 1 Properties and potential applications of various extremozymes produced by Streptomyces strains
Amylases are enzymes that hydrolyze starch into glucose, maltose, and maltotriose units. Native or recombinant amylases are used in various industries such as the detergent industry, textile, leather, paper, food and feed industries and biofuel production. Enzymatic hydrolysis of starch produces simpler oligosaccharides and sugars which find various industrial applications, some of which require a liquefaction or gelatinization step at high temperature (105-110°C) followed by saccharification at a lower temperature (55 to 60°C).69
Extremophilic amylases, particularly thermostable ones, derived from thermophilic actinobacteria of the genus Streptomyces, are in high demand to reduce energy input and make the whole process more profitable and economical. Certain extremophilic actinobacteria have the capacity to produce active and stable amylases at alkaline pH, which are very useful for detergent formulations. Modern laundries prefer detergent formulations based on psychrophilic amylases to wash clothes at low temperatures to save energy.69–72
Cellulases are enzymes that hydrolyze cellulose into glucose, cellobiose and cello-oligosaccharides. Cellulases are commonly used in various industries, including food and feed, textile and laundry, pulp and paper industries as well as the production of biomass-based biofuels.73–76 There is an increased demand for extremophilic cellulases to be exploited in food industries and biorefineries, where thermal processes are used for the bioconversion of cellulose-derived materials. Most cellulases from extremophilic actinobacteria have highly sought-after properties such as good thermostability, strong resistance to acids, high stability to alkalis and excellent stability to detergents. Cellulase from S. drozdowiczii showed enormous potential in the textile and detergent industries thanks to its high activity and stability even in the presence of commercial detergents.73
The acidothermophilic endoglucanase from the extremophilic bacteria Streptomyces DSK59 hydrolyzes pretreated sorghum stalks more efficiently than fungal enzymes, thus releasing a higher level of total reducing sugars.74 Streptomyces sp. strain SirexAA-E (SACTE), isolated from the pine-boring woodwasp Sirex noctilio75 produced and secreted extremophilic cellulases that efficiently degrade and convert plant biomass into small polysaccharides and free sugars.76
Hemicellulases are enzymes that hydrolyze hemicelluloses, such as xylans, xyloglucans, arabinoxylans, and glucomannans from plant biomass. The most influential hemicellulose degrading enzymes are the xylanases and mannanases. They are applied in various fields such as in animal feed, paper and pulp, waste treatment, baking, brewing, and biofuel industries. Xylanases with high stability against temperature, pH and salinity are widely produced by extremophilic actinobacteria.77–82 Extremophilic xylanases and mannanases from S. griseorubens LH-3, S. ipomoea CECT 3341 and S. galbus NR were successfully applied to biobleaching of kraft pulps,77–79 that of S. olivaceus (MSU3) was used for the hydrolysis of agricultural waste for subsequent production of bioethanol.80 The extremophilic xylanases from Streptomyces sp. CS802 and S. chartreusis L1105 showed potential for the synthesis of xylooligosaccharide-type prebiotics.81,82
Pectinases are a group of complex enzymes that degrade the complex pectin. They are used in various industrial processes such as the clarification of fruit juices, the production of functional foods and animal feed, the liquefaction and saccharification of plant biomass, the bio-scouring of cotton fiber, the fermentation of coffee and tea, the production of paper and bioethanol, the retting and degumming of textile fibers, and the treatment of pectic wastewaters. The demand of extremophilic pectinases are continuously increasing. Several researchers succeed in the purification, characterization and applications of many extremophilic pectinases from Streptomyces species.83,87
Chitinases, enzymes that hydrolyze chitin, have attracted interest in numerous industrial applications given their effectiveness in the degradation of chitin in fungal walls and insect exoskeletons. Because of its catalytic potential, they have been applied for the production of chitin oligomers with bioactivities as well as biological control agents against nematodes and phytopathogenic fungi. Streptomyces species are hyperproducers of highly extremophilic extracellular chitinases useful for biocontrol applications in sustainable agriculture.88–92
Proteases or proteolytic enzymes catalyze proteolysis by hydrolysis of peptide bonds. The search for new proteases and their formulations is continuous as they have many applications in industries such as detergents, animal feed, and breweries. Streptomyces have proven to be good producers of proteases with great potential for industrial applications.93–102 Marine S. fungicidicus MML1614 produced thermostable alkaline protease and applied to remove blood stains more effectively than conventional detergents.93 S. koyangensis TN650 produced a detergent-stable and solvent-tolerant alkaline protease, a potential candidate for future application in detergent formulations and non-aqueous peptide biocatalysis.95 Streptomyces sp. MAB18 produced a protease derived from poultry waste that may be useful as a supplemental protein and antioxidant in animal feed formulations.95
Streptomyces strains produced keratinolytic alkaline protease and are good candidates for in detergent formulations, hair removal during leather processing and non- aqueous peptides biocatalysis.96–99 Stable alkaline protease from soil isolates of S. clavuligerus strain Mit-1 and stable and thermostable alkaline protease from Streptomyces sp. DP2 isolates from dairy protein factories and slaughterhouses were characterized. Their alkaline stability and thermostability make them excellent candidates for multiple industrial applications.100,101
Lipases or lipolytic enzymes are ubiquitous triacylglycerol hydrolases that catalyze hydrolysis reactions of triglycerides to glycerol and fatty acids but also esterification, interesterification, transesterification, acidolysis and aminolysis reactions in aqueous and organic media.102–110 Thanks to these multiple and versatile reactions, lipases find various industrial and biotechnological applications, covering different areas such as the production of detergents, foods, polymers, biofuels, fine chemicals, diagnostics and bioremediation. Recently, several studies have focused on the isolation, purification, characterization and applications of extremophilic lipases and esterases from Streptomyces species.102–113 Phospholipases are lipolytic enzymes that hydrolyze the ester bonds of phospholipids. Phospholipases find numerous applications in the food industry, particularly in the bakery, egg and dairy industries since they help reinforce emulsifying properties by acting on the phospholipids already present in food ingredients. Phospholipases D were easy to produce Streptomyces species, catalyze transesterification reactions and, more importantly, were stable under various storage conditions.114,115 The food enzyme phospholipase A2, produced with the genetically modified strain S. violaceoruber AS-10, was distributed on the market under the name PLA2 NAGASE. It was intended for use as an alternative to emulsifiers in many food manufacturing processes, namely the processing of eggs, pastry and bakery processes such as cakes, breads, the degumming of fats and oils and the processing of milk for the production of cheese.116
Finally, it should be noted that certain species of Streptomyces have been recently exploited as promising cell factories for the simultaneous production of numerous secondary metabolites and extracellular extremozymes. To further illustrate this point, we can cite the case of the strain Streptomyces coelicolor A3(2) which has an efficient enzymatic machinery to break down cellulose, hemicelluloses and lignin in plant biomasses. This polyextremophilic strain was also capable of producing more than 17 distinct families of active bioproducts such as actinorhodin, nogalamycin, geosmin and coelimycin P1.117,118 A second example concerns the rhizospheric strain Streptomyces sp. CRPSP2-6A1 which was able to (i) completely metabolize lignocellulosic biomass thanks to the presence of cellulases (endoglucanase and exoglucanase, as well as glucosidases and galactosidases), xylanases (arabinofuranosidases, mannosidases, endohemicellulases, and carboxylesterases) and lignin-degrading peroxidases, (ii) catabolize chitin and chitosan contributing to the metabolism of fungal and insect biomass wastes and (iii) efficiently metabolize various harmful xenobiotic compounds using many other enzymes, such as haloalkane dehalogenase, alkanal monooxygenase, 4-nitrophenol 4-monooxygenase, biphenyl 2,3-dioxygenase, pentachlorophenol 4-monooxygenase, anthranilate 3-monooxygenase, limonene 1-2 monooxygenase, and steroid C26-monooxygenase. The availability of genome sequences of extremophilic Streptomyces strains not only helps in understanding the mechanism of cellulose degradation and stress resistance, but also provides information on secondary metabolic potentials important for the production of various classes of bioactive compounds.
The phylum Actinobacteria represents the largest taxonomic group among the microbial community. The bacteria of this phylum are promising sources for the production of bioactive pharmaceutical compounds but are also considered as biofactories of enzymes with interesting new properties such as great stability in extreme environmental conditions, good tolerance to solvents, remarkable specificity and selectivity of substrates, which open the way to various applications in textiles, tanneries, refineries, human and animal food, detergency, paper industry, pharmaceutical industry, etc. These extremozymes can be used in faster biocatalytic processes, more precise, more specific and more environmentally friendly. However, only a few of the characterized enzymes from actinobacteria in particular belonging to the genus Streptomyces have been studied for real industrial applications. Therefore, it will be interesting to focus in the future on species from other genera of the phylum Actinobacteria like Microbacterium species that produce hyperstable enzymes with concrete examples of applications of these extremozymes in various industrial processes. Moreover, the use of metagenomic approaches will help to better identify and characterize species not yet culturable and their genes encoding extremozymes. Furthermore, the discovery of genomic sequences of polyextremophilic actinobacteria should encourage biotechnologists and manufacturers to embark on the exploration and industrial exploitation of extremozymes hyperproducing-Actinobacteria. The cost of production of these green catalysts could decrease considerably by using cheap substrates or agro-industrial and agricultural wastes, applying the response surface methodology for cultivation process optimization and scaling-up bioreactor production. Developments in protein engineering and directed evolution technologies will enable adaptation and improvement of biocatalytic characteristics, which will increase the application of extremophile-derived enzymes in industry.
This study was supported by the Tunisian Ministry of Higher Education and Scientific Research.
None.
The authors declare, that there is no conflict of interest.

©2024 Gorrab, et al. This is an open access article distributed under the terms of the, which permits unrestricted use, distribution, and build upon your work non-commercially.